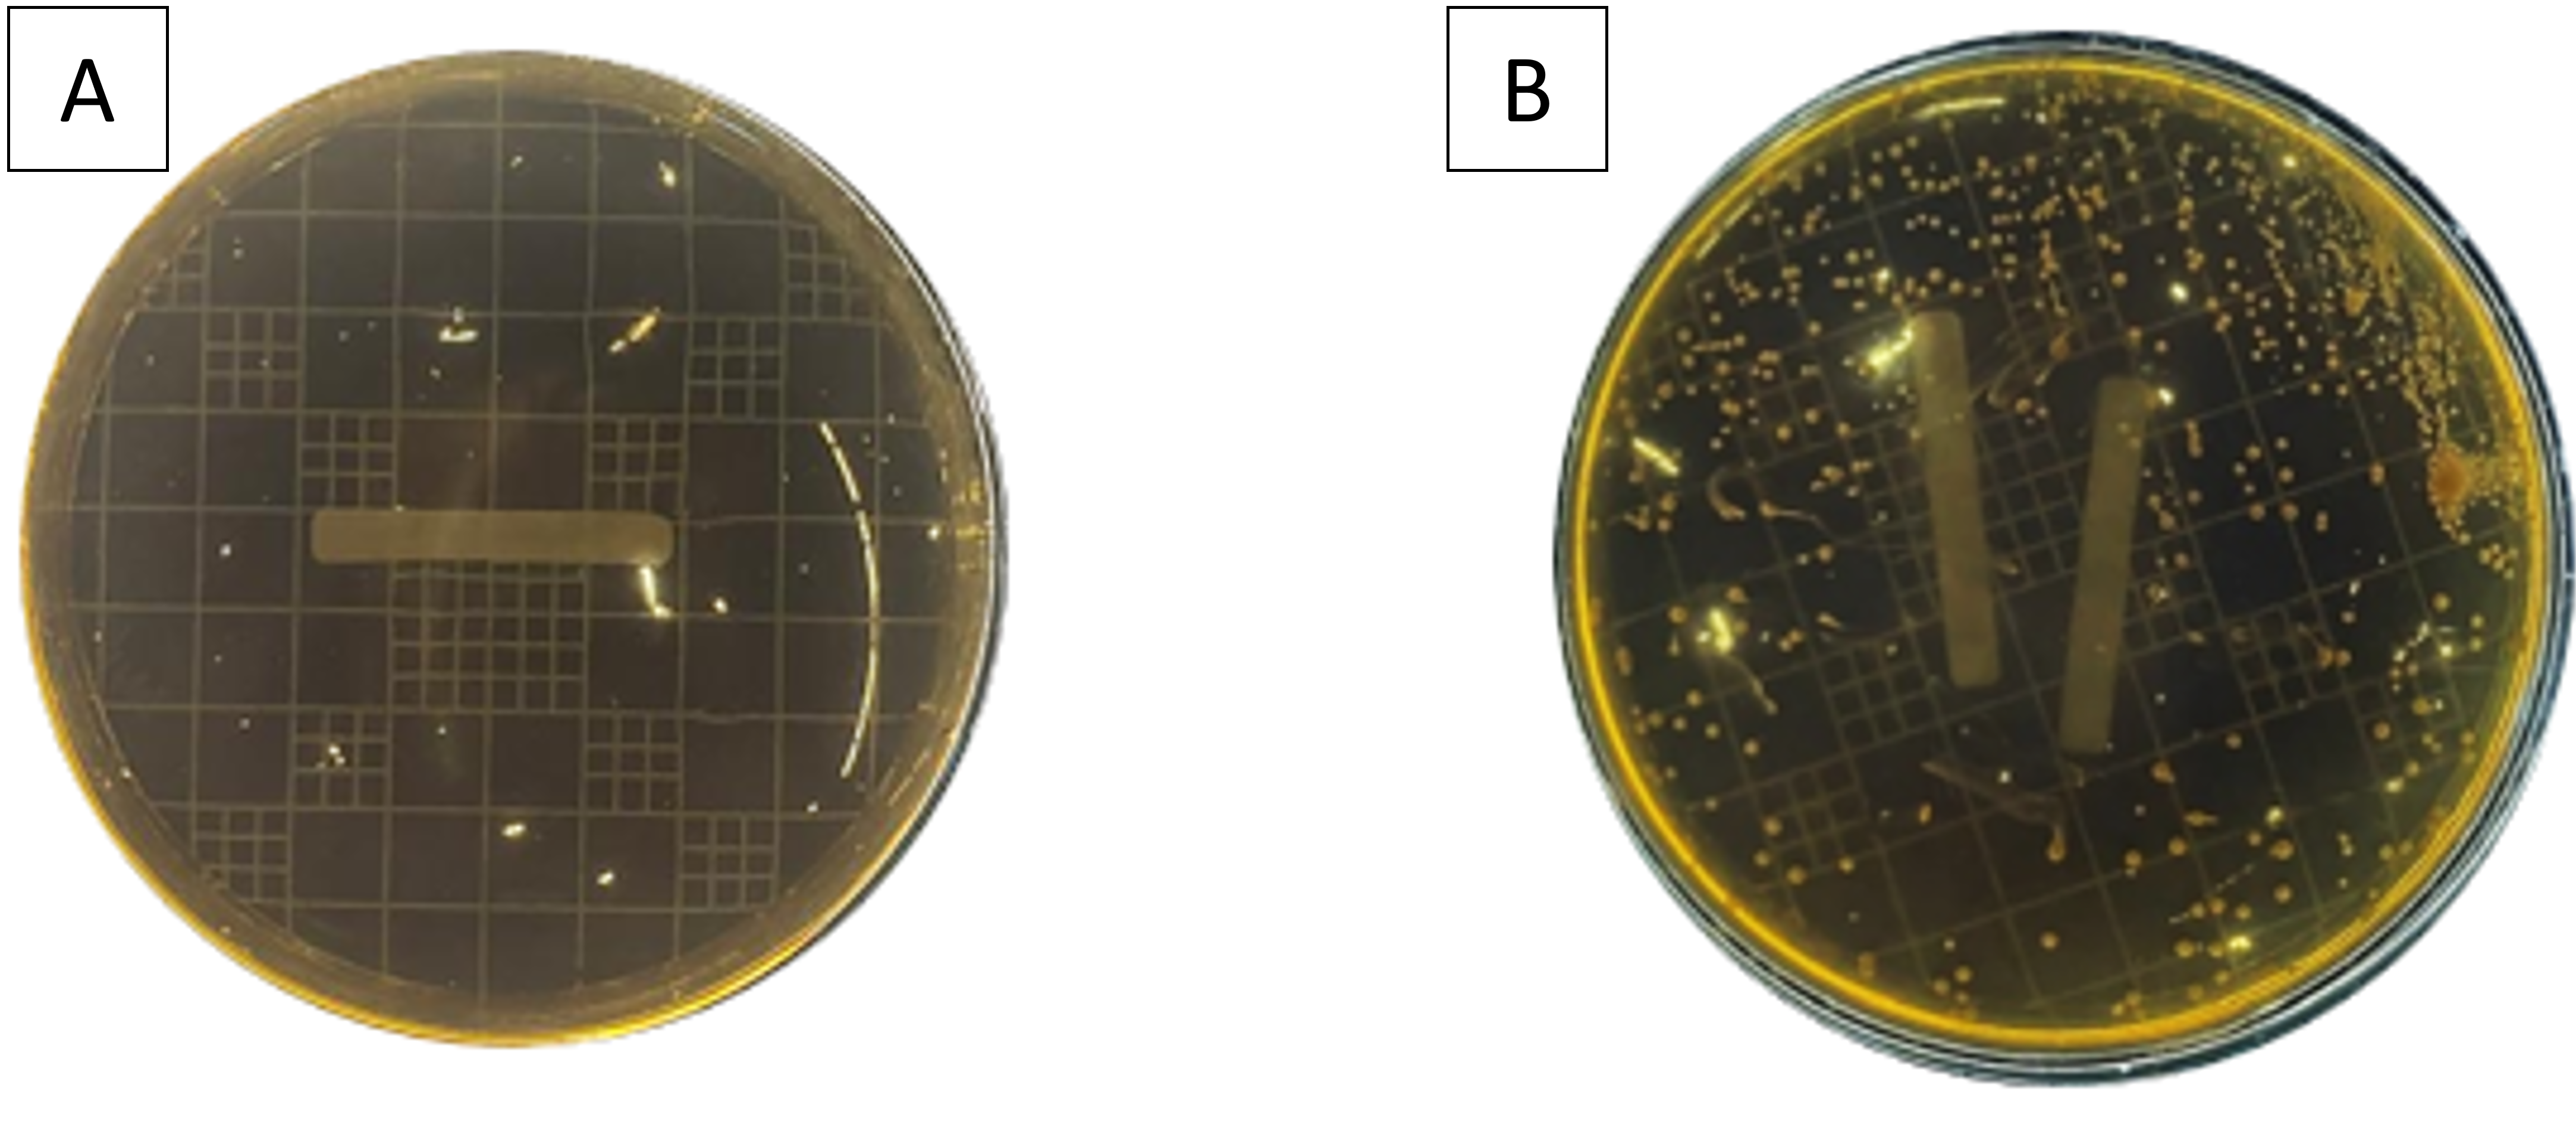
Figure 3. A Control, B Bacterial isolates growing in MRSA medium.

RESEARCH ARTICLE
Potential of Lactic Acid Bacteria from Fermentation of Naniura Tilapia Fish (Oreochromis niloticus) as Exopolysaccharide Producers
Academic Editor: Ramanda Ahmad Rizal Rifa’i
Aquatic Functional Products|Vol. 1, Issue 1, pp. 18-25 (2025)
Received
Aug 14, 2025Revised
Dec 20, 2025Accepted
Dec 25, 2025Published
Dec 30, 2025
Abstract
Naniura is a traditional fermented fish product from North Sumatra that is processed using organic acids derived from Jungga citrus (Citrus hystrix). This study aimed to evaluate the effect of Jungga citrus immersion time on sensory characteristics, physicochemical properties, lactic acid bacteria (LAB) population, and crude exopolysaccharide (EPS) content of tilapia naniura. Fresh tilapia fillets were immersed in Jungga citrus juice at a 1: 1 (w/v) ratio for 0, 3, 4, and 5 h, followed by marination with spices. Sensory evaluation was conducted using hedonic and quality scoring tests with 15 moderately trained panelists. Physicochemical properties (water activity and pH), total LAB counts, LAB characteristics, and crude EPS content were analyzed using standard laboratory methods. The results showed that immersion time significantly affected sensory acceptance, physicochemical properties, LAB population, and EPS content (p < 0.05). The highest hedonic acceptance was obtained at 4 h of immersion, while the highest quality scores, LAB counts, and crude EPS content were observed at 5 h. Increasing immersion time decreased pH and increased water activity, indicating enhanced acid diffusion and protein modification. LAB isolates were identified as Gram-positive, non-motile, heterofermentative bacteria. These findings indicate that Jungga citrus immersion time plays a critical role in determining the sensory quality, microbial activity, and physicochemical stability of tilapia naniura. An immersion time of 4–5 h is recommended to achieve optimal product quality, LAB development, and potential EPS production, supporting the development of safe and functional traditional fermented fish products in Indonesia.
Introduction
Tilapia (Oreochromis niloticus) is a freshwater fish that is widely cultivated in Indonesia, particularly in Pekanbaru, Riau Province. Nutritionally, tilapia contains 14.39% protein, 3.74% carbohydrates, 1.45% fat, and 79.24% moisture per 100 g of edible portion (1). As a fishery commodity, tilapia can be processed into value-added products to improve its economic value and extend its shelf life. Fishery products are generally classified into processed and fermented products, both of which aim to preserve quality and prolong storage stability. Fermentation is a biochemical process that occurs in organic substrates through the activity of enzymes produced by microorganisms and has long been applied as a traditional method of food processing and preservation (2). One traditional fermented fish product is naniura.
Naniura is a traditional Batak Toba dish prepared by soaking raw fish in Jungga citrus juice. The soaking process reduces fishy odor and functions as a natural antibacterial treatment. Naniura has considerable potential as a probiotic food because it contains beneficial microorganisms, particularly lactic acid bacteria (LAB). Jungga citrus possesses high acidity, enabling rapid pH reduction that inhibits spoilage microorganisms (3). he pH of Jungga citrus juice is approximately 2.55 (4). Chemically, immersion in Jungga citrus transforms raw, firm, and fishy fish flesh into a softer product with a distinctive aroma. This transformation is attributed to the presence of essential oils in Jungga citrus that contribute to its characteristic flavor and odor (5).
Several studies have reported the use of Jungga citrus (Citrus hourbhiri) as a natural acidulant in traditional fish processing, especially in naniura production. Jungga citrus contains high concentrations of organic acids, primarily citric acid, which effectively reduce pH, suppress spoilage microorganisms, and enhance sensory attributes such as aroma, color, and texture. Previous studies have demonstrated that soaking fish in Jungga citrus can significantly reduce fishy odor, improve consumer acceptance, and maintain microbiological safety of the final product (6).
Fermented food products are widely recognized as natural sources of lactic acid bacteria (LAB). LAB are commonly isolated from fermented fish, meat, vegetables, and dairy products, and are associated with various health benefits due to their probiotic properties (7). During fermentation, LAB are capable of producing a range of functional metabolites, including organic acids, bacteriocins, and exopolysaccharides (EPS). EPS produced by LAB have attracted increasing attention because of their technological and health-related functions, such as improving texture and water-holding capacity in food systems, as well as exhibiting immunomodulatory activity (8). Therefore, LAB present in naniura fermentation are assumed to possess similar metabolic capabilities, including EPS production.
Lactic acid bacteria, particularly those belonging to the genus Lactobacillus, are known to contribute to host health by enhancing immune responses through stimulation of antibody production, inhibiting the growth of pathogenic microorganisms, restoring intestinal microbial balance, and improving resistance to infections (6). In addition, LAB can survive and adapt to stressful environmental conditions during fermentation by producing EPS, which function as protective polymers surrounding bacterial cells.
Exopolysaccharides are extracellular polysaccharides secreted by bacteria in response to environmental stress, such as acidic conditions, osmotic pressure, and nutrient limitation. EPS play important roles in protecting bacterial cells against bacteriophages, phagocytosis, toxic compounds, and osmotic stress, as well as facilitating biofilm formation. Moreover, EPS have been reported to exhibit health-promoting properties, including immunostimulatory and antitumor activities, as well as the ability to enhance macrophage and lymphocyte function (8). However, information regarding the potential of LAB from tilapia naniura fermentation as EPS producers is still limited.
Therefore, this study was conducted to evaluate the quality characteristics of tilapia naniura, isolate and characterize lactic acid bacteria, and determine the potential of LAB from tilapia (Oreochromis niloticus) naniura fermentation as producers of exopolysaccharides.
Methodology
Time and Places
This research was conducted from May to June 2025 at the Fisheries Product Processing Laboratory and the Fisheries Product Microbiology Laboratory, Faculty of Fisheries and Marine Sciences, University of Riau. During this period, the study focused on experimental procedures, including sample preparation and laboratory analysis, whereas data processing and manuscript preparation were conducted separately after the experimental phase.
Materials
The materials used for naniura preparation were fresh tilapia (Oreochromis niloticus) obtained from a local traditional market, Jungga citrus (Citrus hourbhiri), andaliman (Zanthoxylum acanthopodium), turmeric (Curcuma longa), ginger (Zingiber officinale), garlic (Allium sativum), red onion (Allium cepa), candlenut (Aleurites moluccanus), galangal (Alpinia galanga), and red chili (Capsicum annuum). The tilapia used in this study were processed in fresh condition without freezing.
Materials used for lactic acid bacteria isolation included de Man Rogosa and Sharpe Agar (MRSA), de Man Rogosa and Sharpe Broth (MRSB), Nutrient Agar (NA), Nutrient Broth (NB), physiological NaCl solution, and distilled water. Materials used for crude exopolysaccharide analysis included MRSB medium and technical-grade acetone. Consumable materials included distilled water, tissue paper, and labeling materials.
Research method
The method used in this study was experimental, namely isolating lactic acid bacteria and testing the crude exopolysaccharide content. The design used in this study was a non-factorial completely randomized design (CRD) with treatment variations in immersion time consisting of 4 treatment levels, namely 0 h (L0), 3 h (L3), 4 h (L4), and 5 h (L5). The experimental approach was selected to evaluate the effect of immersion time on the measured response under controlled conditions. All treatments were conducted following the same procedural steps to maintain consistency across experimental units. The design model used was as shown in Eq. 1.
Eq. 1. | Yij = Observation values for treatment i and repetition j, µ = Actual mean, τi = Effect of treatment i, εij = Experimental error in treatment i and repetition j.
Research procedure
Making Naniura
The production of naniura involved several stages. Fresh tilapia were first cleaned and cut into butterfly fillets by slicing from the dorsal side toward the tail, then drained. Fresh tilapia fillets (±100 g per treatment) were immersed in freshly squeezed Jungga citrus juice at a 1: 1 (w/v) ratio, equivalent to approximately 110 mL of juice per 100 g of fish, ensuring that the fillets were fully submerged. The immersion in Jungga citrus juice was carried out for 0, 3, 4, and 5 h according to the treatment design. Following completion of the citrus immersion, the spices were ground using a blender and mixed evenly. The fish fillets were then separately marinated with naniura spices for an additional 1 hour, which was applied equally to all treatments. The product was then observed and considered ready for consumption (9).
Isolation and purification of lactic acid bacteria isolates
The first stage of isolation and purification of lactic acid bacteria isolates is dilution, by homogenizing 10 g of the naniura sample in 90 mL of physiological NaCl to obtain a 10⁻¹ dilution. The dilution process is continued up to 10⁻⁵ by transferring 1 mL of the previous dilution into 9 mL of physiological saline. Then, 1 mL of sample from the last three dilution series (10⁻³, 10⁻⁴, and 10⁻⁵) is transferred into a petri dish and added with 15–20 mL of MRSA medium. Bacterial growth on the MRSA medium is performed in duplicate for each dilution and the petri dishes are incubated at 37°C for 24 h. Selected colonies showing the largest clear zones and distinct morphology were purified on MRSA medium using the quadrant streak method at 37°C for 24 h, with repeated streaking performed when necessary to obtain uniform colonies (10). The isolation and purification workflow is presented in Figure 1.

Observation
Sensory Evaluation
Sensory evaluation consisted of a hedonic test and a sensory quality test, both conducted to evaluate the acceptance and quality characteristics of naniura products (11). The tests were performed using 15 moderately trained panelists, who were undergraduate students of Fisheries Product Technology.
The hedonic test was carried out to determine panelists’ preference toward the samples. Panelists evaluated appearance, aroma, taste, and texture using a 9-point hedonic scale, where 1 = extremely dislike and 9 = extremely like.
The sensory quality test was conducted to assess the overall quality attributes of the product, including appearance, aroma, taste, and texture. A quality scoring method was applied using a 1–5 scale, where 1 = very poor quality and 5 = very good quality.
All samples were coded with random three-digit numbers and presented to panelists at room temperature. Drinking water was provided between evaluations to neutralize the palate.
Analysis of water activity values
The water activity value of the sausage was measured using a pre-calibrated water activity meter. A total of 4 g of crushed naniura was placed in a measuring cup. The device was used until it showed the “completed” sign (12).
pH test
pH determination can be performed using a pH meter. The equipment prepared for pH testing includes a pH meter, electrode glass, and a magnetic stirrer. This pH measurement begins with calibrating the pH meter with a buffer solution; the pH meter is always calibrated before each measurement. The cleaned electrode is immersed in the sample to be measured, and the result indicated by the needle on the pH meter is recorded (13).
Total lactate acid bacteria test
Equation 2 | N = total lactic acid bacteria (CFU/g), ΣC = total colonies counted, n1 and n2 = numbers of plates at selected dilutions, d = lowest dilution factor.
Lactat acid bacteria characterization
Morphological test
Morphological observation of lactic acid bacteria colonies. Morphological observation of colonies was performed after obtaining pure cultures. Macroscopic observation included the shape, color, edges, and elevation of bacterial colonies. The surface of the colony could be viewed from the side, and the edges of the colony could be viewed from above the dish (15).
Gram staining
A 24-hour-old bacterial culture is placed on a sterile slide and fixed. Crystal violet staining solution is added to the slide with the bacterial culture and left for 1 min. The slide is rinsed with a small amount of running water. This staining uses a crystal violet solution as the primary stain to color the target microorganisms purple. Next, Lugol's iodine solution is added to the slide and left for 30 s to 1 min. The Lugol's iodine solution is brown in color to enhance the color of the crystal violet. The slide is rinsed with a small amount of running water and left to dry briefly. Then, the slide is gradually dripped with 95% ethanol until no dye flows out of the slide, and rinsed with running water. Next, safranin solution is added to the specimen and left for 1 min. Safranin stains microorganisms red, then the specimen is rinsed with running water and dried. The specimen is observed under a microscope at magnifications of 100x, 400x, and up to 1000x (16).
Catalase test
One bacterial culture was taken from the 24-hour-old MRSB growth medium and placed on a glass slide. One to two drops of 3% hydrogen peroxide (H₂O₂) reagent were added to the surface of the glass slide containing the culture and left for a few moments. Observe whether bubbles form on the slide containing the isolate. If bubbles form, it indicates that the bacteria are catalase-positive, and if no bubbles form, it indicates that the bacteria are catalase-negative (17).
Motility test
To determine the motility of lactic acid bacteria, each isolate was inoculated by piercing with an ose needle into Sulfide Indole Motility (SIM) semi-solid medium and then incubated in an incubator for 24-48 h at 37°C. If bacterial growth on the SIM medium spreads (outside the puncture area), the bacteria are motile. If bacterial growth is limited to the puncture area, the bacteria are non-motile (18).
Type of fermentation test
The fermentation test is used to classify lactic acid bacteria into homofermentative or heterofermentative groups. The fermentation test is performed by growing bacterial cultures in liquid MRS medium in reaction tubes containing Durham tubes. Incubation is carried out for 2 days at 37°C. Observations are made by observing the formation of air bubbles in the Durham tubes (3).
Testing Crude Exopolysaccharide Levels
The final stage involved testing crude EPS production (19) by inoculating 8 ose BAL into 50 mL of MRSB medium and incubating it for 24 h at 35°C. Following this, cold centrifugation was performed for 30 min at a concentration of 5000 rpm and a temperature of 4°C. Then, 20 mL of the supernatant from the centrifugation was transferred into a reaction tube that had previously been weighed, followed by the addition of 40 mL of technical acetone (twice the volume of the sample) and left overnight at 4°C. Then, centrifuge again for 30 min at 5000 rpm and 4°C, discard the supernatant, and dry the pellet at the bottom of the tube in an oven at 100°C for 15 min. Weigh the tube containing the dry EPS, subtract the original weight of the empty tube, and determine the constant weight. The yield is calculated using the Eq. 3.
Data Analysis
The data obtained was first tabulated into a table and analyzed statistically using analysis of variance (ANOVA) with SPSS version 21. Based on the analysis of variance, if F-Calculated < F-Table at a 95% confidence level, then H0 is accepted. If F-Calculated > F-Table at a 95% confidence level, then H0 is rejected, and a further test is conducted.
Results and Discussion
Sensory Evaluation
Sensory evaluation was conducted to assess panelists’ preference and perceived quality of tilapia naniura subjected to different Jungga citrus immersion times. The evaluation was based on appearance, aroma, taste, and texture parameters.
Hedonic Value
Hedonic evaluation was conducted to determine panelists’ preference toward tilapia naniura based on appearance, aroma, taste, and texture. Differences in Jungga citrus soaking duration influenced panelists’ responses, as indicated by variations in hedonic values among treatments.
Figure 2 shows the visual appearance of tilapia naniura after immersion in Jungga citrus for different durations. Changes in color and surface characteristics were observed with increasing soaking time, which contributed to differences in panelists’ sensory perception.

The hedonic scores for appearance, aroma, taste, and texture of tilapia naniura are summarized in Table 1. Overall, immersion time significantly affected all hedonic parameters (p < 0.05).
| Soaking time (h) | Appearance | Aroma | Taste | Texture |
|---|---|---|---|---|
| 0 hour (L0) | 3.64 ± 0.10ᵃ | 4.04 ± 0.08ᵃ | 3.40 ± 0.07ᵃ | 3.56 ± 0.21ᵃ |
| 3 hour (L3) | 6.27 ± 0.07ᵇ | 6.53 ± 0.07ᵇ | 5.53 ± 0.07ᵇ | 6.64 ± 0.10ᶜ |
| 4 hour (L4) | 8.47 ± 0.07ᵈ | 8.49 ± 0.04ᵈ | 8.67 ± 0.13ᵈ | 8.56 ± 0.04ᵈ |
| 5 hour (L5) | 7.47 ± 0.07ᶜ | 7.27 ± 0.24ᶜ | 6.27 ± 0.12ᶜ | 5.40 ± 0.13ᵇ |
| Values are expressed as mean ± standard deviation. Different superscript letters in the same column indicate significant differences (p < 0.05). | ||||
The highest hedonic scores for all sensory attributes were observed in tilapia naniura immersed in Jungga citrus for 4 h (L4). At this immersion time, the product exhibited a bright and appealing appearance, a reduced fishy odor with a distinctive acidic aroma, a balanced sour taste that remained acceptable to panelists, and a soft yet compact texture. In contrast, the lowest hedonic scores were recorded for the 0-hour immersion treatment (L0), indicating limited sensory acceptability when the fish was not soaked in Jungga citrus (20).
Prolonged immersion for 5 h (L5) decreased hedonic scores for taste and texture compared to 4 h, likely due to excessive acid exposure that intensified sourness and weakened muscle structure (56, 154, 149);"> 21). In contrast, a 4 h Jungga citrus immersion produced tilapia naniura with the highest consumer acceptance across all hedonic parameters, indicating that appropriate acid soaking duration is critical for optimal sensory quality.
Quality Score
Quality scoring was conducted to evaluate the objective quality attributes of tilapia naniura based on predefined criteria, including appearance, aroma, taste, and texture. Unlike hedonic assessment, which reflects panelists’ preferences, quality scoring describes the product characteristics in relation to standard quality attributes.
The quality scores of tilapia naniura subjected to different Jungga citrus immersion times are presented in Table 2. Immersion time significantly affected all quality parameters (p < 0.05).
| Soaking time (h) | Appearance | Aroma | Taste | Texture |
|---|---|---|---|---|
| 0 hour (L0) | 3.56 ± 0.10ᵃ | 4.24 ± 0.17ᵃ | 4.20 ± 0.18ᵃ | 4.27 ± 0.07ᵃ |
| 3 hour (L3) | 6.33 ± 0.07ᵇ | 6.44 ± 0.17ᵇ | 6.38 ± 0.08ᵇ | 7.18 ± 0.04ᵇ |
| 4 hour (L4) | 7.38 ± 0.08ᶜ | 7.20 ± 0.23ᶜ | 7.33 ± 0.07ᶜ | 7.58 ± 0.14ᶜ |
| 5 hour (L5) | 8.33 ± 0.07ᵈ | 8.49 ± 0.10ᵈ | 8.22 ± 0.10ᵈ | 8.20 ± 0.07ᵈ |
| Values are expressed as mean ± standard deviation. Different superscript letters in the same column indicate significant differences (p < 0.05). | ||||
The highest quality scores for all attributes were observed in tilapia naniura immersed in Jungga citrus for 5 h (L5). This treatment resulted in a bright yellow-orange appearance, a strong citrus and spice aroma without fishy odor, a well-balanced sour and spicy taste, and a very tender texture. These characteristics indicate that prolonged acid immersion enhances product quality by intensifying color, aroma, and flavor while softening muscle structure.
In contrast, the lowest quality scores were obtained from the 0-hour immersion treatment (L0), indicating limited quality development when Jungga citrus was not applied. Increasing immersion time allowed the organic acids and spices to penetrate the fish tissue more effectively, contributing to improved sensory quality.
However, although the 5-hour immersion treatment (L5) produced the highest quality scores, this treatment did not correspond to the highest hedonic preference. This suggests that excessive acid exposure may improve objective quality attributes while reducing consumer preference, highlighting the importance of optimizing immersion time in naniura processing.
Physicochemical Properties (Water Activity and pH)
Water activity (Aw) and pH are important physicochemical parameters that influence the quality, stability, and safety of fermented fish products. In this study, both parameters were evaluated to determine the effect of Jungga citrus immersion time on tilapia naniura.
The Aw and pH values of tilapia naniura subjected to different Jungga citrus immersion times are presented in Table 3. Immersion time significantly affected both Aw and pH values (p < 0.05).
| Soaking time (h) | Aw | pH |
|---|---|---|
| 0 (L0) | 0.61 ± 0.01ᵃ | 5.40 ± 0.09ᶜ |
| 3 (L3) | 0.64 ± 0.01ᵃᵇ | 4.63 ± 0.09ᵇ |
| 4 (L4) | 0.67 ± 0.01ᵇ | 4.35 ± 0.09ᵃ |
| 5 (L5) | 0.71 ± 0.02ᶜ | 4.21 ± 0.08ᵃ |
| Values are expressed as mean ± standard deviation. Different superscript letters in the same column indicate significant differences (p < 0.05). | ||
Increasing immersion time in Jungga citrus resulted in a gradual increase in Aw values and a corresponding decrease in pH. The lowest pH value and the highest Aw value were observed in the 5-hour immersion treatment (L5), whereas the highest pH and lowest Aw were recorded in the 0-hour treatment (L0). Acidification and water availability changed.
The decrease in pH with increasing immersion time can be attributed to the diffusion of organic acids, primarily citric acid, from Jungga citrus into the fish muscle. Citric acid lowers the pH of the product by increasing the hydrogen ion concentration, creating an acidic environment within the muscle tissue. Prolonged exposure to acid promotes protein denaturation, which alters the muscle structure and reduces the water-binding capacity of myofibrillar proteins. The increase in Aw observed with longer immersion times is closely related to these structural changes. Acid-induced denaturation weakens the interaction between proteins and bound water, leading to the release of bound water into free water. Consequently, the amount of free water in the product increases, resulting in higher Aw values. Similar trends have been reported in acid-treated fish products, where prolonged soaking leads to increased free water content due to protein structural modification.
From a food safety perspective, the reduction in pH contributes positively to microbial stability by inhibiting the growth of spoilage and pathogenic microorganisms. However, the increase in Aw may enhance microbial activity if not balanced by sufficient acidity. Therefore, immersion time plays a critical role in determining the balance between physicochemical stability and microbial safety of naniura. Overall, the results indicate that Jungga citrus immersion time strongly influences both Aw and pH values of tilapia naniura. While longer immersion times improve acidity and may enhance microbial safety, excessive increases in Aw should be carefully considered to maintain product stability. These findings highlight the importance of optimizing immersion duration to achieve desirable physicochemical properties and ensure food safety.
Total Lactate-Producing Bacteria (BAL)
The BAL values of tilapia naniura with different acid immersion times are shown in Table 4. Immersion time significantly affected BAL counts (p < 0.05).
| Soaking time (h) | Repetition | Mean (CFU/g) |
|---|---|---|
| 0 (L0) | 3.5 × 10⁴, 4.0 × 10⁴, 4.6 × 10⁴ | 4.0 × 10⁴ᵃ |
| 3 (L3) | 5.6 × 10⁴, 6.5 × 10⁴, 6.1 × 10⁴ | 6.1 × 10⁴ᵇ |
| 4 (L4) | 2.8 × 10⁵, 3.0 × 10⁵, 2.9 × 10⁵ | 2.9 × 10⁵ᶜ |
| 5 (L5) | 3.7 × 10⁵, 3.7 × 10⁵, 3.2 × 10⁵ | 3.5 × 10⁵ᶜ |
| Values are expressed as mean ± standard deviation. Different superscript letters in the same column indicate significant differences (p < 0.05). | ||
Increasing immersion time led to higher BAL counts, with the highest in the 5-hour treatment (L5) and lowest in the 0-hour treatment (L0). ANOVA analysis confirmed significant effects of immersion time on BAL (F_calculated = 62405.27 > F_table = 4.07, 95% confidence level), and BNJ post-hoc test showed that L4 and L5 were not significantly different, whereas L0 and L3 differed significantly.
The increase in BAL with longer immersion is due to the favorable acidic environment for lactic acid bacteria, which supports fermentation while inhibiting spoilage microorganisms. The mean BAL value of 4.3 × 10⁵ CFU/g also complies with SNI 01-2779.1-2006, which sets a maximum total plate count for fresh fish at 5 × 10⁵ CFU/g.
These findings indicate that acid Jungga immersion time strongly influences both physicochemical properties and microbial activity in tilapia naniura. Longer immersion times improve acidity and promote lactic acid bacterial growth, enhancing fermentation quality and food safety. However, increases in Aw should be monitored to maintain product stability. Optimizing immersion duration is therefore crucial to achieve desirable physicochemical characteristics, microbial safety, and overall product quality. To support the interpretation of BAL dynamics, water activity (Aw) and pH measurements are included. These parameters provide additional context for the microbial environment during the fermentation process. The observed values are presented to describe prevailing conditions without implying direct causal relationships. These indicators summarize product changes during immersion, ensuring conclusions remain grounded in physicochemical and microbiological parameters.
Characteristics of Lactic Acid Bacteria
Isolation of tilapia naniura using different levels of jungga acid immersion yielded 12 isolates that grew on MRS agar medium. To determine the characteristics of lactic acid bacteria, macroscopic testing was conducted to observe the morphological characteristics of the colonies, microscopic testing was conducted to observe the morphology of the cells, and biochemical testing was also conducted (22). The results of the BAL isolates can be seen in Figure 3.
Table 5 shows that BAL has a white and cream color, indicating that the bacteria contain carotenoid pigments. The color of the growing colonies appears different due to the pigments produced by the bacteria.
| Macroscopic characteristics | Microscopic characteristics | |||||
|---|---|---|---|---|---|---|
| Isolate | Color | Edge | Elevation | Shape | Gram | Shape |
| L03 | White | Rata | Convex | Round | + | Bacillus |
| L04 | White | Rata | Convex | Round | + | Bacillus |
| L05 | White | Rata | Convex | Round | + | Bacillus |
| L33 | White | Rata | Convex | Round | + | Bacillus |
| L34 | White | Rata | Convex | Round | + | Bacillus |
| L35 | Cream | Rata | Convex | Round | + | Bacillus |
| L43 | White | Rata | Convex | Round | + | Bacillus |
| L44 | White | Rata | Convex | Round | + | Bacillus |
| L45 | White | Rata | Convex | Round | + | Bacillus |
| L53 | White | Rata | Convex | Round | + | Bacillus |
| L54 | White | Rata | Convex | Round | + | Bacillus |
| L55 | Cream | Rata | Convex | Round | + | Bacillus |
Gram staining
Gram staining is a classification of bacteria that divides bacteria into two major groups, namely gram-positive and gram-negative, based on the physical and chemical components that make up the cell wall. The results of Gram staining can be seen in Figure 4.

Gram staining of BAL on the 12-nanocell isolates revealed Gram-positive bacteria with a rod shape (7). This indicates that Gram-positive bacteria retain the purple color of crystal violet because their cell walls contain more peptidoglycan, while Gram-negative bacteria lose the purple color and retain a pink color due to lower peptidoglycan content. Further identification based on biochemical characterization of the bacterial isolates is shown in Table 6 and Figure 5.
| No | Isolate sample | Type of test | ||
|---|---|---|---|---|
| Catalase test | Motility test | Type of fermentation | ||
| 1. | L03 | - | Non motile | Heterofermentative |
| 2. | L04 | - | Non motile | Heterofermentative |
| 3. | L05 | - | Non motile | Heterofermentative |
| 4 | L33 | - | Non motile | Heterofermentative |
| 5 | L34 | - | Non motile | Heterofermentative |
| 6 | L35 | - | Non motile | Heterofermentative |
| 7 | L43 | - | Non motile | Heterofermentative |
| 8 | L44 | - | Non motile | Heterofermentative |
| 9 | L45 | - | Non motile | Heterofermentative |
| 10 | L53 | - | Non motile | Heterofermentative |
| 11 | L54 | - | Non motile | Heterofermentative |
| 12 | L55 | - | Non motile | Heterofermentative |

The catalase test showed that naniura tilapia with different jungga acid immersions produced 12 isolates that had undergone a catalase test using hydrogen peroxide (H2O2) with negative results, where no bubbles formed on the object glass containing H2O2 liquid when coated with bacteria.
From the observation of the motility of the 12 BAL isolates inoculated into SIM medium, the results were negative or non-motile. The motility test was conducted because one of the characteristics of BAL is that it is non-motile. Bacteria are considered motile if their growth spreads around the inoculation site and causes turbidity in the medium, while bacteria are considered non-motile if their growth does not spread and only forms a line along the inoculation site.
Heterofermentative is characterized by the formation of air bubbles in the Durham tube. BAL that produces lactic acid, carbon dioxide (CO₂), and ethanol belongs to the heterofermentative group, while BAL that produces lactic acid as the primary product of glucose fermentation is called homofermentative.
Table 7 shows that the crude EPS content of tilapia naniura with different jungga acid immersion times had the highest value in naniura with an immersion time of 5 h (L5) and the lowest in naniura with an immersion time of 0 h (L0). Based on the results of the analysis of variance, it was found that naniura with different acid soaking times had a significant effect on the crude EPS content of naniura tilapia, with F calculated (906534.58) > F table (4.07) at a 95% confidence level, thus rejecting H0 and conducting a further test. The BNJ post-hoc test showed that L0, L3, L4, and L5 were significantly different. Table 7 shows that the crude EPS content of tilapia naniura with different acid soaking periods had the highest value in naniura with a soaking period of 5 h (L5) and the lowest in naniura with a soaking period of 0 h (L0).
| Soaking period | Repetition | Mean | ||
|---|---|---|---|---|
| 1 | 2 | 3 | ||
| 0 hour (L0) | 1.170 | 1.175 | 1.175 | 1.173±2.89a |
| 3 hour (L3) | 3.185 | 3.185 | 3.188 | 3.185±2.55b |
| 4 hour (L4) | 3.352 | 3.350 | 3.353 | 3.351±1.67c |
| 5 hour (L5) | 3.863 | 3.865 | 3.865 | 3.864±0.96d |
According to, the maximum EPS production by a culture is influenced by the growth factors of that culture, where optimal EPS production occurs during maximum cell production, which is during the stationary phase or the final phase of BAL. Another opinion is presented by, who states that other factors that can influence the amount of EPS produced by BAL, besides incubation time, include excess carbohydrates in the medium, the type of medium used, fermentation conditions such as temperature, pH, and oxygen levels, as well as bacterial physiology (23).
Conclusion
Jungga citrus immersion time significantly influences the sensory quality, physicochemical characteristics, lactic acid bacteria population, and crude exopolysaccharide content of tilapia naniura. Sensory evaluation demonstrated that a 4-hour immersion time resulted in the highest consumer preference, while longer immersion enhanced objective quality attributes, microbial activity, and EPS production. Increasing immersion time led to lower pH values and higher water activity, reflecting organic acid diffusion and protein structural modification that affect product texture and stability.
The presence and growth of lactic acid bacteria under acidic conditions indicate that Jungga citrus immersion supports a favorable fermentation environment while contributing to microbial safety. Furthermore, the increased EPS production at longer immersion times suggests potential functional properties that may be beneficial for food texture and health-related applications. Overall, optimizing Jungga citrus immersion time is essential to balance sensory acceptance, physicochemical stability, and microbial quality. This study highlights the potential of naniura as a safe traditional fermented fish product and supports the utilization of lactic acid bacteria and exopolysaccharides for the development of value-added fermented foods in Indonesia.
Declarations
Conflict of Interest
The authors declare no conflicting interest.
Data Availability
The unpublished data is available upon request to the corresponding author.
Funding Information
The author(s) declare that no financial support was received for the research, authorship, and/or publication of this article.
References
- Rahardjo AA. Evaluasi kualitas air dan kualitas ikan yang dibudidayakan dengan keramba jaring apung pada perairan Waduk Jatiluhur [thesis]. Semarang: Universitas Katolik Soegijapranata; 2019.
- Azzahra U, Julita W, Achyar A. Pengaruh lama fermentasi dalam pembuatan tape singkong (Manihot utilissima). Prosiding SEMNAS BIO. 2022.
- Petalia P. Pengaruh berbagai jenis asam jeruk terhadap perubahan mutu ikan mas naniura selama waktu display [thesis]. Medan: Universitas Sumatera Utara; 2016.
- Tarigan OJ, Lestari S, Widiastuti I. Pengaruh jenis asam dan lama marinasi terhadap karakteristik sensoris, mikrobiologis, dan kimia naniura ikan nila (Oreochromis niloticus). J Teknol Hasil Perikanan. 2016; 5 (2): 112–22.
- Manalu MB. Memperkenalkan naniura makanan khas Batak sebagai hidangan appetizer. Maj Ilm Panorama Nusantara. 2009; 7.
- Rusli R, Amalia F, Dwyana Z. Potensi bakteri Lactobacillus acidophilus sebagai antidiare dan imunomodulator. BIOMA J Biol Makassar. 2018; 3 (2).
- Aisyah A, Kusdiyantini E, Suprihadi A. Isolasi, karakterisasi bakteri asam laktat, dan analisis proksimat dari pangan fermentasi “tempoyak. ” J Akademika Biologi [Internet]. 2014 May 13 [cited 2025 Dec 31]; 3 (2): 31–9.
- Giyatno DC, Retnaningrum E. Isolasi dan karakterisasi bakteri asam laktat penghasil eksopolisakarida dari buah kersen (Muntingia calabura L. ). J Sains Dasar. 2021; 9 (2): 42–9.
- Pakpahan IF, Sumardianto S, Fahmi AS. Pengaruh lama waktu perendaman bumbu yang berbeda terhadap karakteristik naniura ikan mas (Cyprinus carpio). J Ilmu Teknol Perikanan. 2020; 2 (2): 7–12.
- Harley JP. Laboratory exercises in microbiology. 6th ed. New York: McGraw-Hill; 2005.
- Badan Standardisasi Nasional. SNI 01-2346-2006: Petunjuk pengujian organoleptik dan sensori. Jakarta: BSN; 2006.
- AOAC. Official methods of analysis. 18th ed. Washington DC: Association of Official Analytical Chemists; 2005. Methods 935.14, 992.24.
- Badan Standardisasi Nasional. SNI 01-2891-1992: Cara uji makanan dan minuman. Jakarta: BSN; 1992.
- Badan Standardisasi Nasional. Cara uji mikrobiologi – Bagian 3: Penentuan angka lempeng total (ALT) pada produk perikanan. Jakarta: BSN; 2015.
- Hadioetomo RS. Mikrobiologi dasar dalam praktek. Jakarta: PT Gramedia Pustaka Utama; 1993.
- Holt JG, Krieg NR, Sneath PHA, Staley JT, Williams ST. Bergey’s manual of determinative bacteriology. Baltimore: Williams & Wilkins; 1994. p. 786–8.
- Romadhon R, Subagiyo S, Margino S. Isolasi dan karakterisasi bakteri asam laktat dari usus udang penghasil bakteriosin sebagai agen antibakteria pada produk hasil perikanan. J Saintek Perikanan. 2012; 8.
- Tallon R, Bressollier P, Urdaci MC. Isolation and characterization of two exopolysaccharides produced by Lactobacillus plantarum EP56. Res Microbiol. 2003; 154 (10): 705–12.
- Hutapea CN, Leksono T, Sari NI. The effect of different kinds of citrus on the quality of jelawat fish (Leptobarbus hoevenii) naniura. Berkala Perikanan Terubuk [Internet]. 2019 Nov 14 [cited 2025 Dec 31]; 47 (2): 165.
- Pakpahan IF, Sumardianto S, Fahmi AS. Pengaruh lama waktu perendaman bumbu yang berbeda terhadap karakteristik naniura ikan mas (Cyprinus carpio). J Ilmu Teknol Perikanan [Internet]. 2020 Dec 3 [cited 2025 Dec 31]; 2 (2): 7–12.
- Savitri SDN. Isolasi dan karakterisasi bakteri halotoleran pada peda ikan kembung (Rastrelliger sp. ) [thesis]. Bogor: Institut Pertanian Bogor; 2006.
- Putri AA. Isolasi bakteri asam laktat genus Lactobacillus dari feses rusa sambar (Cervus unicolor) [thesis].
- Lawalata HJ, Kumajas J, Tengker SM, Runtuwene KM, Hasani RS, Weken MM. Lactic acid bacteria as an exopolysaccharides (EPS) producing starter from Pakoba fruit (Syzygium sp. ), endemic species at Minahasa, North Sulawesi. J Pure Appl Microbiol. 2023; 17 (4): 2536–46.